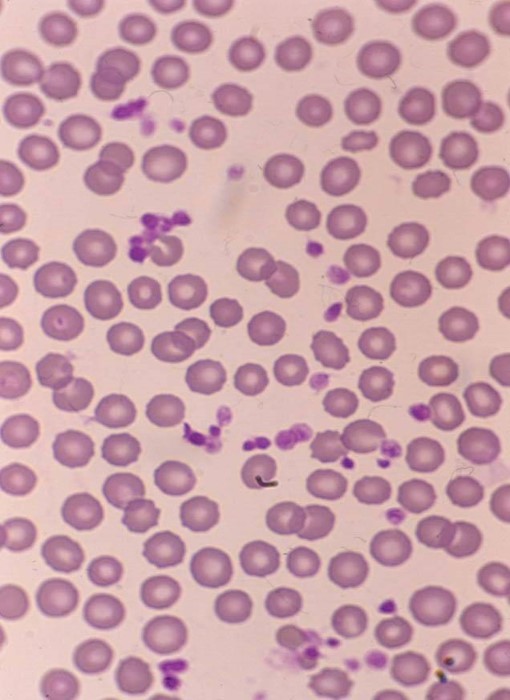
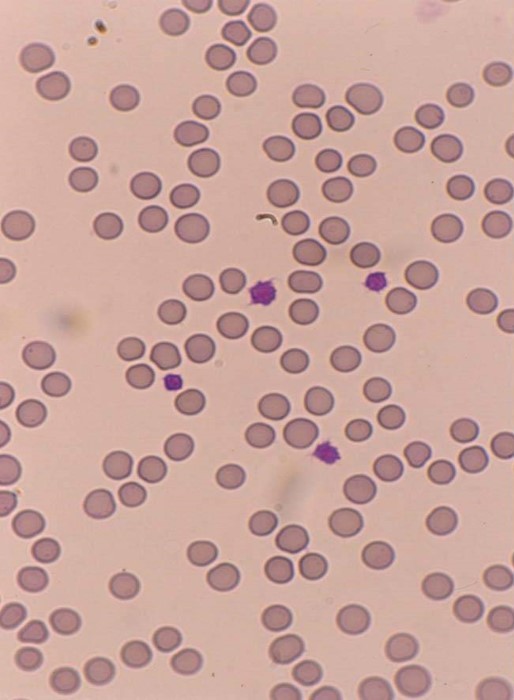
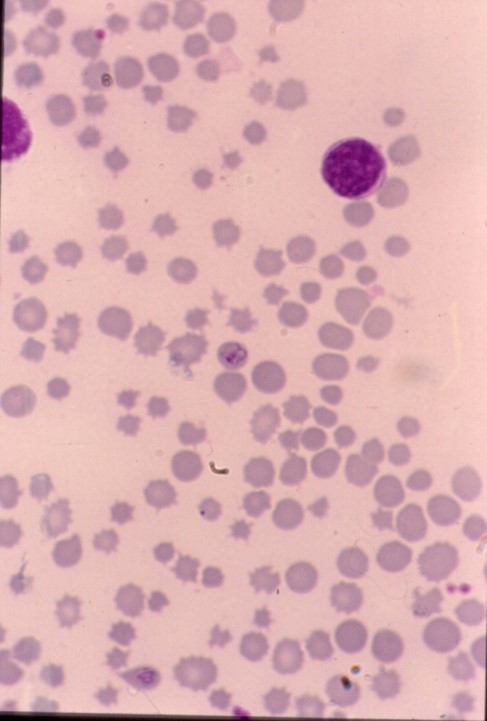

What are the components of blood?
What are the functions of blood?
Transport
Ion buffer – fluid/electrolyte homeostasis
Coagulation
Thermoregulation
What are reticulocytes?

Young (immature/non-nucleated) erythrocytes prematurely released to blood from the bone marrow in regenerative anaemias.
How do you visualise reticulocytes?
New methylene blue (NMB) precipitation demonstrates
What appearance do reticulocytes have on romanowsky stain?
Polychromatophil
Bottom pic

What are the clinical applications of reticulocytes?
Evaluation of erythropoiesis in bone marrow
Differentiation of regenerative and non-regenerative anaemia
What is this?

Reticulocytes
What can be seen?

Clumps of ribosomal RNA & mitochondria
How can we count reticulocytes?
How do you calculate absolute reticulocyet count?
observed % reticulocytes x RBC (x1012/l) x 10
Reticulocytes in dogs:
A) How many is normal?
B) How many do we expect in regeneratve anaemia?
A) Low number of reticulocytes (<1%)
B) Expect at least (>60x109/L) in regenerative anaemias
Cat reticulocyte:
A) How many is normal?
B) What are the 2 morphological types?
C) Which is the only type we consider in regeneration?
D) How many do we expect in regenerative anaemia?
A) Low number of reticulocytes (0.2-1.6%)
B)
C) Aggregate in assessment of regeneration
D) Expect at least (>50x109/L) in regenerative anaemia
How many reticulocytes are in normal ruminant and horse blood?
Virtually none
When is the peak production of reticulocytes in cattle post blood loss?
7-14 days
What animal is this and why?
Dog
What species is this and why?
Cat:
Smaller erythrocytes
Anisocytosis (variation in size)
Scarce central pallor (less concave)
What species is this and why?

Horse:
Rouleaux
(sedimentation tendency)
What species is this and why?
Ruminant
Anisocytosis and crenation
What is the blood variation in:
A) Poodles?
B) Akitas?
C) Greyhounds?
A) Macrocytosis
B) Small erythrocytes and high potassium
C) High PCV
How do we measure RBC size?
MCV (fL) – mean corpuscular volume
= PCV (L/L) X1000 / RBC count (1012/L)
What is normocytosis?
Normal range of RBC size
What can cause macrocytosis? (3)
What can cause microcytosis?
Iron deficiency
What is red cell distribution width?
A numeric representation of the variability in RBC size
More sensitive than MCV